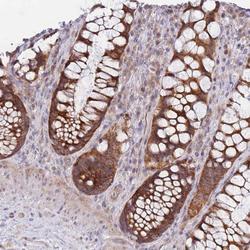

Antibody data
- Antibody Data
- Antigen structure
- References [0]
- Comments [0]
- Validations
- Immunohistochemistry [1]
Submit
Validation data
Reference
Comment
Report error
- Product number
- PA5-62195 - Provider product page

- Provider
- Invitrogen Antibodies
- Product name
- Anti-OR51G1 Polyclonal Antibody
- Antibody type
- Polyclonal
- Antigen
- Recombinant full-length protein
- Description
- Immunogen sequence: SIKTKQIRQR IIKKFQFIKS LRC Highest antigen sequence identity to the following orthologs: Mouse - 78%, Rat - 74%.
- Reactivity
- Human
- Host
- Rabbit
- Isotype
- IgG
- Vial size
- 100 µl
- Concentration
- Lot-Specific
- Storage
- Store at 4°C short term. For long term storage, store at -20°C, avoiding freeze/thaw cycles.
No comments: Submit comment
Supportive validation
- Submitted by
- Invitrogen Antibodies (provider)
- Main image
- Experimental details
- Immunohistochemical staining of OR51G1 in human rectal tissue shows strong cytoplasmic positivity in glandular cells. Samples were probed using an OR51G1 Polyclonal Antibody (Product # PA5-62195).